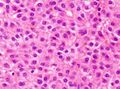

سرطان الخلايا الكبدية
| Hepatocellular carcinoma | |
|---|---|
| الأسماء الأخرى | Hepatoma |
 | |
| Hepatocellular carcinoma in an individual who was hepatitis C positive. Autopsy specimen. | |
| التخصص | Oncology |
Hepatocellular carcinoma (HCC[1]) is the most common type of primary liver cancer in adults and is currently the most common cause of death in people with cirrhosis.[2] HCC is the third leading cause of cancer-related deaths worldwide.[3]
It occurs in the setting of chronic liver inflammation, and is most closely linked to chronic viral hepatitis infection (hepatitis B or C) or exposure to toxins such as alcohol, aflatoxin, or pyrrolizidine alkaloids. Certain diseases, such as hemochromatosis and alpha 1-antitrypsin deficiency, markedly increase the risk of developing HCC. Metabolic syndrome and NASH are also increasingly recognized as risk factors for HCC.[4]
As with any cancer, the treatment and prognosis of HCC vary depending on the specifics of tumor histology, size, how far the cancer has spread, and overall health.
The vast majority of HCC cases and the lowest survival rates after treatment occur in Asia and sub-Saharan Africa, in countries where hepatitis B infection is endemic and many are infected from birth. The incidence of HCC in the United States and other developing countries is increasing due to an increase in hepatitis C virus infections. It is more than four times as common in males as in females, for unknown reasons.[4]
Signs and symptoms
Most cases of HCC occur in people who already have signs and symptoms of chronic liver disease. They may present with worsening symptoms or without symptoms at the time of cancer detection. HCC may present with non-specific symptoms such as abdominal pain, nausea, vomiting, or feeling tired.[5] Some symptoms that are more closely associated with liver disease include yellow skin (also called jaundice), abdominal swelling due to fluid in the abdominal cavity, easy bruising from blood clotting abnormalities, loss of appetite, unintentional weight loss, abdominal pain, nausea, vomiting, or feeling tired.[5]
Risk factors
Since HCC mostly occurs in people with cirrhosis of the liver, risk factors generally include factors which cause chronic liver disease that may lead to cirrhosis. Still, certain risk factors are more highly associated with HCC than others. For example, while heavy alcohol consumption is estimated to cause 60–70% of cirrhosis, the vast majority of HCC occurs in cirrhosis attributed to viral hepatitis (although there may be overlap).[6] Recognized risk factors include:
- Chronic viral hepatitis (estimated cause of 80% cases globally)
- Chronic hepatitis B (about 50% cases)
- Chronic hepatitis C (about 25% cases)[7]
- Toxins:
- Alcohol use disorder: the most common cause of cirrhosis[6]
- Aflatoxin
- Iron overload state (hemochromatosis)
- Pyrrolizidine alkaloids
- Metabolic:
- Nonalcoholic steatohepatitis: up to 20% progress to cirrhosis [8]
- Nonalcoholic fatty liver disease[9]
- Type 2 diabetes (probably aided by obesity)[10]
- Congenital disorders:
- Alpha 1-antitrypsin deficiency
- Wilson's disease (controversial; while some theorise the risk increases,[11] case studies are rare[12] and suggest the opposite where Wilson's disease actually may confer protection[13])
- Hemophilia, although statistically associated with higher risk of HCC,[14] this is due to coincident chronic viral hepatitis infection related to repeated blood transfusions over lifetime.[1]
The significance of these risk factors varies globally. In regions where hepatitis B infection is endemic, such as southeast China, hepatitis B is the predominant cause.[15] In populations largely protected by hepatitis B vaccination, such as the United States, HCC is most often linked to causes of cirrhosis such as chronic hepatitis C, obesity, and excessive alcohol use.[16]
Certain benign liver tumors, such as hepatocellular adenoma, may sometimes be associated with coexisting malignant HCC. Evidence is limited for the true incidence of malignancy associated with benign adenomas; however, the size of hepatic adenoma is considered to correspond to risk of malignancy and so larger tumors may be surgically removed. Certain subtypes of adenoma, particularly those with β-catenin activation mutation, are particularly associated with increased risk of HCC.[16]
Chronic liver disease is rare in children and adolescents; however, congenital liver disorders are associated with an increased the chance of developing HCC.[17] Specifically, children with biliary atresia, infantile cholestasis, glycogen-storage diseases, and other cirrhotic diseases of the liver are predisposed to developing HCC in childhood.[citation needed]
Young adults afflicted by the rare fibrolamellar variant of hepatocellular carcinoma may have none of the typical risk factors, such as cirrhosis and hepatitis.[16]
Diabetes mellitus
The risk of hepatocellular carcinoma in type 2 diabetics is greater (from 2.5[10] to 7.1[18] times the nondiabetic risk) depending on the duration of diabetes and treatment protocol. A suspected contributor to this increased risk is circulating insulin concentration such that diabetics with poor insulin control or on treatments that elevate their insulin output (both states that contribute to a higher circulating insulin concentration) show far greater risk of hepatocellular carcinoma than diabetics on treatments that reduce circulating insulin concentration.[10][18][19][20] On this note, some diabetics who engage in tight insulin control (by keeping it from being elevated) show risk levels low enough to be indistinguishable from the general population.[18][19] This phenomenon is thus not isolated to diabetes mellitus type 2, since poor insulin regulation is also found in other conditions such as metabolic syndrome (specifically, when evidence of nonalcoholic fatty liver disease or NAFLD is present) and again evidence of greater risk exists here, too.[21][22] While there are claims that anabolic steroid abusers are at greater risk[23] (theorized to be due to insulin and IGF exacerbation[24][25]), the only evidence that has been confirmed is that anabolic steroid users are more likely to have the benign hepatocellular adenomas transform into the more dangerous hepatocellular carcinoma.[26][27]
Pathogenesis
Hepatocellular carcinoma, like any other cancer, develops when epigenetic alterations and mutations affecting the cellular machinery cause the cell to replicate at a higher rate and/or result in the cell avoiding apoptosis.[28]
In particular, chronic infections of hepatitis B and/or C can aid the development of hepatocellular carcinoma by repeatedly causing the body's own immune system to attack the liver cells, some of which are infected by the virus, others merely bystanders.[29] Activated immune-system inflammatory cells release free radicals, such as reactive oxygen species and nitric oxide reactive species, which in turn can cause DNA damage and lead to carcinogenic gene mutations.[30] Reactive oxygen species also cause epigenetic alterations at the sites of DNA repair.[31]
While this constant cycle of damage followed by repair can lead to mistakes during repair, which in turn lead to carcinogenesis, this hypothesis is more applicable, at present, to hepatitis C. Chronic hepatitis C causes HCC through the stage of cirrhosis. In chronic hepatitis B, however, the integration of the viral genome into infected cells can directly induce a noncirrhotic liver to develop HCC. Alternatively, repeated consumption of large amounts of ethanol can have a similar effect. The toxin aflatoxin from certain Aspergillus species of fungi is a carcinogen and aids carcinogenesis of hepatocellular cancer by building up in the liver. The combined high prevalence of rates of aflatoxin and hepatitis B in settings such as China and West Africa has led to relatively high rates of hepatocellular carcinoma in these regions. Other viral hepatitides such as hepatitis A have no potential to become a chronic infection, thus are not related to HCC.[16]
Diagnosis
Methods of diagnosis in HCC have evolved with the improvement in medical imaging. The evaluation of both asymptomatic patients and those with symptoms of liver disease involves blood testing and imaging evaluation. Historically, a biopsy of a tumor was required to prove an HCC diagnosis. However, imaging (especially MRI) findings may be conclusive enough to obviate histopathologic confirmation.[16]
Screening
HCC remains associated with a high mortality rate, in part because initial diagnosis commonly occurs at an advanced stage of disease. As with other cancers, outcomes are significantly improved if treatment is initiated earlier in the disease process. Since the vast majority of HCC cases occur in people with certain chronic liver diseases, especially those with cirrhosis, liver screening is commonly advocated in this population. Specific screening guidelines continue to evolve over time as evidence of its clinical impact becomes available. In the United States, the most commonly observed guidelines are those published by the American Association for the Study of Liver Diseases(AASLD), which recommends ultrasound screenings every six months for people with cirrhosis, with or without measurement of blood levels of tumor marker alpha-fetoprotein (AFP).[32] Elevated levels of AFP are associated with active HCC disease, though their reliability can be inconsistent. At levels >20, sensitivity is 41–65% and specificity is 80–94%. However, at levels >200, sensitivity is 31 and specificity is 99%.[33]
On ultrasound, HCC often appears as a small hypoechoic lesion with poorly defined margins and coarse, irregular internal echoes. When the tumor grows, it can sometimes appear heterogeneous with fibrosis, fatty change, and calcifications. This heterogeneity can look similar to cirrhosis and the surrounding liver parenchyma. A systematic review found that the sensitivity was 60% (95% CI 44–76%) and specificity was 97% (95% CI 95–98%) compared with pathologic examination of an explanted or resected liver as the reference standard. The sensitivity increases to 79% with AFP correlation.[34]
Controversy remains as to the most effective screening protocols. For example, while some data support decreased mortality related to screening people with hepatitis B infection, the AASLD notes, “There are no randomized trials [for screening] in Western populations with cirrhosis secondary to chronic hepatitis C or fatty liver disease, and thus there is some controversy surrounding whether surveillance truly leads to a reduction in mortality in this population of patients with cirrhosis.”[32]
Higher risk people
In a person where a higher suspicion of HCC exists, such as a person with symptoms or abnormal blood tests (i.e. alpha-fetoprotein and des-gamma carboxyprothrombin levels),[35] evaluation requires imaging of the liver by CT or MRI scans. Optimally, these scans are performed with intravenous contrast in multiple phases of hepatic perfusion to improve detection and accurate classification of any liver lesions by the interpreting radiologist. Due to the characteristic blood flow pattern of HCC tumors, a specific perfusion pattern of any detected liver lesion may conclusively detect an HCC tumor. Alternatively, the scan may detect an indeterminate lesion and further evaluation may be performed by obtaining a physical sample of the lesion.[16][36]
Imaging

Ultrasound, CT scan, and MRI may be used to evaluate the liver for HCC. On CT and MRI, HCC can have three distinct patterns of growth:[citation needed]
- A single large tumor
- Multiple tumors
- Poorly defined tumor with an infiltrative growth pattern
A systematic review of CT diagnosis found that the sensitivity was 68% (95% CI 55–80%) and specificity was 93% (95% CI 89–96%) compared with pathologic examination of an explanted or resected liver as the reference standard. With triple-phase helical CT, the sensitivity was 90% or higher, but these data have not been confirmed with autopsy studies.[34]
However, MRI has the advantage of delivering high-resolution images of the liver without ionizing radiation. HCC appears as a high-intensity pattern on T2-weighted images and a low-intensity pattern on T1-weighted images. The advantage of MRI is that it has improved sensitivity and specificity when compared to ultrasound and CT in cirrhotic patients with whom it can be difficult to differentiate HCC from regenerative nodules. A systematic review found that the sensitivity was 81% (95% CI 70–91%) and specificity was 85% (95% CI 77–93%) compared with pathologic examination of an explanted or resected liver as the reference standard.[34] The sensitivity is further increased if gadolinium contrast-enhanced and diffusion-weighted imaging are combined.
MRI is more sensitive and specific than CT.[37]
Liver image reporting and data system (LI-RADS) is a classification system for the reporting of liver lesions detected on CT and MRI. Radiologists use this standardized system to report on suspicious lesions and to provide an estimated likelihood of malignancy. Categories range from LI-RADS (LR) 1 to 5, in order of concern for cancer.[38] A biopsy is not needed to confirm the diagnosis of HCC if certain imaging criteria are met.[16]
Pathology
Macroscopically, liver cancer appears as a nodular or infiltrative tumor. The nodular type may be solitary (large mass) or multiple (when developed as a complication of cirrhosis). Tumor nodules are round to oval, gray or green (if the tumor produces bile), well circumscribed but not encapsulated. The diffuse type is poorly circumscribed and infiltrates the portal veins, or the hepatic veins (rarely).[16]
Microscopically, the four architectural and cytological types (patterns) of hepatocellular carcinoma are: fibrolamellar, pseudoglandular (adenoid), pleomorphic (giant cell), and clear cell. In well-differentiated forms, tumor cells resemble hepatocytes, form trabeculae, cords, and nests, and may contain bile pigment in the cytoplasm. In poorly differentiated forms, malignant epithelial cells are discohesive, pleomorphic, anaplastic, and giant. The tumor has a scant stroma and central necrosis because of the poor vascularization.[39] A fifth form – lymphoepithelioma like hepatocellular carcinoma – has also been described.[40][41]
Staging
BCLC Staging System
The prognosis of HCC is affected by the staging of the tumor and the liver's function due to the effects of liver cirrhosis.[42]
A number of staging classifications for HCC are available. However, due to the unique nature of the carcinoma to fully encompass all the features that affect the categorization of the HCC, a classification system should incorporate tumor size and number, presence of vascular invasion and extrahepatic spread, liver function (levels of serum bilirubin and albumin, presence of ascites, and portal hypertension) and general health status of the patient (defined by the ECOG classification and the presence of symptoms).[42]
Of all the staging classification systems available, the Barcelona Clinic Liver Cancer staging classification encompasses all of the above characteristics. This staging classification can be used to select people for treatment.[43]
| Stage | Description | Child-Pugh class | ECOG performance status |
|---|---|---|---|
| 0 (very early stage) | Single nodule, < 3 cm | A | 0 |
| A (early stage) | 1–3 nodule, all < 3 cm | A or B | |
| B (intermediate stage) | Multi-nodular tumor | ||
| C (advanced stage) | Portal invasion and extra-hepatic spread | 1 or 2 | |
| D (terminal stage) | Severe liver damage | C | 3 or 4 |
Important features that guide treatment include:
- size
- spread (stage)
- involvement of liver vessels
- presence of a tumor capsule
- presence of extrahepatic metastases
- presence of daughter nodules
- vascularity of the tumor
MRI is the best imaging method to detect the presence of a tumor capsule.
The most common sites of metastasis are the lung, abdominal lymph nodes, and bone.[47]
Prevention
Since hepatitis B and C are some of the main causes of hepatocellular carcinoma, prevention of infection is key to then prevent HCC. Thus, childhood vaccination against hepatitis B may reduce the risk of liver cancer in the future.[48] In the case of patients with cirrhosis, alcohol consumption is to be avoided. Also, screening for hemochromatosis may be beneficial for some patients.[49] Whether screening those with chronic liver disease for HCC improves outcomes is unclear.[50]
Treatment
Treatment of hepatocellular carcinoma varies by the stage of disease, a person's likelihood to tolerate surgery, and availability of liver transplant:
- Curative intention: for limited disease, when the cancer is limited to one or more areas of within the liver, surgically removing the malignant cells may be curative. This may be accomplished by resection the affected portion of the liver (partial hepatectomy) or in some cases by orthotopic liver transplantation of the entire organ.[citation needed]
- "Bridging" intention: for limited disease which qualifies for potential liver transplantation, the person may undergo targeted treatment of some or all of the known tumor while waiting for a donor organ to become available.[51]
- "Downstaging" intention: for moderately advanced disease which has not spread beyond the liver, but is too advanced to qualify for curative treatment. The person may be treated by targeted therapies in order to reduce the size or number of active tumors, with the goal of once again qualifying for liver transplant after this treatment.[51]
- Palliative intention: for more advanced disease, including spread of cancer beyond the liver or in persons who may not tolerate surgery, treatment intended to decrease symptoms of disease and maximize duration of survival.[citation needed]
Loco-regional therapy (also referred to as liver-directed therapy) refers to any one of several minimally-invasive treatment techniques to focally target HCC within the liver. These procedures are alternatives to surgery, and may be considered in combination with other strategies, such as a later liver transplantation.[52] Generally, these treatment procedures are performed by interventional radiologists or surgeons, in coordination with a medical oncologist. Loco-regional therapy may refer to either percutaneous therapies (e.g. cryoablation), or arterial catheter-based therapies (chemoembolization or radioembolization).[citation needed]
Surgical resection
Surgical removal of the tumor is associated with better cancer prognosis, but only 5–15% of patients are suitable for surgical resection due to the extent of disease or poor liver function.[53] Surgery is only considered if the entire tumor can be safely removed while preserving sufficient functional liver to maintain normal physiology. Thus, preoperative imaging assessment is critical to determine both the extent of HCC and to estimate the amount of residual liver remaining after surgery. To maintain liver function, residual liver volume should exceed 25% of total liver volume in a noncirrhotic liver, greater than 40% in a cirrhotic liver.[54] Surgery on diseased or cirrhotic livers is generally associated with higher morbidity and mortality. The overall recurrence rate after resection is 50–60%. The Singapore Liver Cancer Recurrence score can be used to estimate risk of recurrence after surgery.[55]
Liver transplantation
Liver transplantation, replacing the diseased liver with a cadaveric or a living donor liver, plays an increasing role in treatment of HCC. Although outcomes following liver transplant were initially poor (20%–36% survival rate),[16] outcomes have significantly improved with improvement in surgical techniques and adoption of the Milan criteria at US transplantation centers. Expanded Shanghai criteria in China have resulted in overall survival and disease-free survival rates similar to those achieved using the Milan criteria.[56] Studies from the late 2000s obtained higher survival rates ranging from 67% to 91%.[57]
The risks of liver transplantation extend beyond risk of the procedure itself. The immunosuppressive medication required after surgery to prevent rejection of the donor liver also impairs the body's natural ability to combat dysfunctional cells. If the tumor has spread undetected outside the liver before the transplant, the medication effectively increases the rate of disease progression and decreases survival. With this in mind, liver transplant "can be a curative approach for patients with advanced HCC without extrahepatic metastasis".[58] In fact, among patients with compensated cirrhosis, transplantation is not associated with improved survival compared to hepatectomy, but instead is significantly more expensive.[59] Patient selection is considered a major key for success.[60]
Ablation
- Radiofrequency ablation (RFA) uses high-frequency radio waves to destroy tumor by local heating. The electrodes are inserted into the liver tumor under ultrasound image guidance using percutaneous, laparoscopic or open surgical approach. It is suitable for small tumors (<5 cm). RFA has the best outcomes in patients with a solitary tumor less than 4 cm.[61] Since it is a local treatment and has minimal effect on normal healthy tissue, it can be repeated multiple times. Survival is better for those with smaller tumors. In one study, In one series of 302 patients, the three-year survival rates for lesions >5 cm, 2.1 to 5 cm, and ≤2 cm were 59, 74, and 91%, respectively.[62] A large randomized trial comparing surgical resection and RFA for small HCC showed similar four-year survival and less morbidities for patients treated with RFA.[63]
- Cryoablation is a technique used to destroy tissue using cold temperature. The tumor is not removed and the destroyed cancer is left to be reabsorbed by the body. Initial results in properly selected patients with unresectable liver tumors are equivalent to those of resection. Cryosurgery involves the placement of a stainless steel probe into the center of the tumor. Liquid nitrogen is circulated through the end of this device. The tumor and a half inch margin of normal liver are frozen to −190 °C for 15 minutes, which is lethal to all tissues. The area is thawed for 10 minutes and then refrozen to −190 °C for another 15 minutes. After the tumor has thawed, the probe is removed, bleeding is controlled, and the procedure is complete. The patient spends the first postoperative night in the intensive care unit and typically is discharged in 3–5 days. Proper selection of patients and attention to detail in performing the cryosurgical procedure are mandatory to achieve good results and outcomes. Frequently, cryosurgery is used in conjunction with liver resection, as some of the tumors are removed while others are treated with cryosurgery.[citation needed]
- Percutaneous ethanol injection is well tolerated, with high RR in small (<3 cm) solitary tumors; as of 2005, no randomized trial has comparing resection to percutaneous treatments; recurrence rates are similar to those for postresection. However, a comparative study found that local therapy can achieve a 5-year survival rate around 60% for patients with small HCC.[64]
Arterial catheter-based treatment
- Transcatheter arterial chemoembolization (TACE) is performed for unresectable tumors or as a temporary treatment while waiting for liver transplant ("bridge to transplant"). TACE is done by injecting an antineoplastic drug (e.g. cisplatin) mixed with a radio-opaque contrast (e.g. Lipiodol) and an embolic agent (e.g. Gelfoam) into the right or left hepatic artery via the groin artery. The goal of the procedure is to restrict the tumor's vascular supply while supplying a targeted chemotherapeutic agent. TACE has been shown to increase survival and to downstage HCC in patients who exceed the Milan criteria for liver transplant. Patients who undergo the procedure are followed with CT scans and may need additional TACE procedures if the tumor persists.[65] As of 2005, multiple trials show objective tumor responses and slowed tumor progression, but questionable survival benefit compared to supportive care; greatest benefit is seen in people with preserved liver function, absence of vascular invasion, and smallest tumors. TACE is not suitable for big tumors (>8 cm), the presence of portal vein thrombus, tumors with a portal-systemic shunt, and patients with poor liver function.[citation needed]
- Selective internal radiation therapy (SIRT) can be used to destroy the tumor from within (thus minimizing exposure to healthy tissue). Similar to TACE, this is a procedure in which an interventional radiologist selectively injects the artery or arteries supplying the tumor with a chemotherapeutic agent. The agent is typically Yttrium-90 (Y-90) incorporated into embolic microspheres that lodge in the tumor vasculature, causing ischemia and delivering their radiation dose directly to the lesion. This technique allows for a higher, local dose of radiation to be delivered directly to the tumor while sparing normal healthy tissue. While not curative, patients have increased survival. No studies have been done to compare whether SIRT is superior to TACE in terms of survival outcomes, although retrospective studies suggest similar efficacy.[66] Two products are available, SIR-Spheres and TheraSphere. The latter is an FDA-approved treatment for primary liver cancer (HCC) which has been shown in clinical trials to increase the survival rate of low-risk patients. SIR-Spheres are FDA-approved for the treatment of metastatic colorectal cancer, but outside the US, SIR-Spheres are approved for the treatment of any nonresectable liver cancer including primary liver cancer.[67]
External beam therapy
- The role of radiotherapy in the treatment of hepatocellular carcinoma has evolved as technological advancements in treatment delivery and imaging have provided a means for safe and effective radiotherapy delivery in a wide spectrum of HCC patients. In metastatic cases, radiotherapy can be used for palliative care.[68][69]
- Proton therapy for unresectable hepatocellular carcinoma was associated with improved survival relative to photon-based radiation therapy which may be driven by decreased incidence of post-treatment liver decompensation[70] and a number of randomized controlled trials are currently ongoing.[71][72][73]
Systemic
In disease which has spread beyond the liver, systemic therapy may be a consideration. In 2007, Sorafenib, an oral multikinase inhibitor, was the first systemic agent approved for first-line treatment of advanced HCC.[74] Trials have found modest improvement in overall survival: 10.7 months vs 7.9 months and 6.5 months vs 4.2 months.[75][74]
The most common side effects of Sorafenib include a hand-foot skin reaction and diarrhea.[75] Sorafenib is thought to work by blocking growth of both tumor cells and new blood vessels. Numerous other molecular targeted drugs are being tested as alternative first- and second-line treatments for advanced HCC.[76]
A host of additional targeted therapies and immune checkpoint inhibitors have been found to be effective against this disease. For instance, in the recent phase III trial IMBrave 150, the combination of atezolizumab and bevacizumab was found to improve both overall and progression-free survival compared to sorafenib alone.[77]
Tremelimumab (Imjudo) was approved for medical use in the United States in October 2022.[78] It is indicated, in combination with durvalumab, for the treatment of adults with unresectable hepatocellular carcinoma.[78]
Other
- Portal vein embolization (PVE): This technique is sometimes used to increase the volume of healthy liver, in order to improve chances of survival following surgical removal of diseased liver. For example, embolization of the right main portal vein would result in compensatory hypertrophy of the left lobe, which may qualify the patient for a partial hepatectomy. Embolization is performed by an interventional radiologist using a percutaneous transhepatic approach. This procedure can also serve as a bridge to transplant.[79]
- High intensity focused ultrasound (HIFU) (as opposed to diagnostic ultrasound) is an experimental technique which uses high-powered ultrasound waves to destroy tumor tissue.
- A systematic review assessed 12 articles involving a total of 318 patients with hepatocellular carcinoma treated with Yttrium-90 radioembolization.[80] Excluding a study of only one patient, post-treatment CT evaluation of the tumor showed a response ranging from 29 to 100% of patients evaluated, with all but two studies showing a response of 71% or greater.
Prognosis
The usual outcome is poor because only 10–20% of hepatocellular carcinomas can be removed completely using surgery. If the cancer cannot be completely removed, the disease is usually deadly within 3 to 6 months.[81][المصدر لا يؤكد ذلك] This is partially due to late presentation with tumors, but also the lack of medical expertise and facilities in the regions with high HCC prevalence. However, survival can vary, and occasionally people survive much longer than 6 months. The prognosis for metastatic or unresectable HCC has improved due to the approval of Sorafenib (Nexavar®) for advanced HCC.[citation needed]
Epidemiology


HCC is one of the most common tumors worldwide. The epidemiology of HCC exhibits two main patterns, one in North America and Western Europe and another in non-Western countries, such as those in sub-Saharan Africa, Central and Southeast Asia, and the Amazon basin. Males are affected more than females usually, and it is most common between the ages of 30 and 50,[84] Hepatocellular carcinoma causes 662,000 deaths worldwide per year[85] about half of them in China.
Africa and Asia
In some parts of the world, such as sub-Saharan Africa and Southeast Asia, HCC is the most common cancer, generally affecting men more than women, and with an age of onset between the late teens and 30s.[16] This variability is in part due to the different patterns of hepatitis B and hepatitis C transmission in different populations – infection at or around birth predispose to earlier cancers than if people are infected later. The time between hepatitis B infection and development into HCC can be years, even decades, but from diagnosis of HCC to death, the average survival period is only 5.9 months according to one Chinese study during the 1970-80s, or 3 months (median survival time) in sub-Saharan Africa according to Manson's textbook of tropical diseases. HCC is one of the deadliest cancers in China, where chronic hepatitis B is found in 90% of cases. In Japan, chronic hepatitis C is associated with 90% of HCC cases. Foods infected with Aspergillus flavus (especially peanuts and corns stored during prolonged wet seasons) which produces aflatoxins pose another risk factor for HCC.[citation needed]
North America and Western Europe
The most common malignant tumors in the liver represent metastases (spread) from tumors which originate elsewhere in the body.[84] Among cancers that originate from liver tissue, HCC is the most common primary liver cancer. In the United States, the US surveillance, epidemiology, and end results database program, shows that HCC accounts for 65% of all cases of liver cancers.[86] As screening programs are in place for high-risk persons with chronic liver disease, HCC is often discovered much earlier in Western countries than in developing regions such as sub-Saharan Africa.[citation needed]
Acute and chronic hepatic porphyrias (acute intermittent porphyria, porphyria cutanea tarda, hereditary coproporphyria, variegate porphyria) and tyrosinemia type I are risk factors for hepatocellular carcinoma. The diagnosis of an acute hepatic porphyria (AIP, HCP, VP) should be sought in patients with HCC without typical risk factors of hepatitis B or C, alcoholic liver cirrhosis, or hemochromatosis. Both active and latent genetic carriers of acute hepatic porphyrias are at risk for this cancer, although latent genetic carriers have developed the cancer at a later age than those with classic symptoms. Patients with acute hepatic porphyrias should be monitored for HCC.[citation needed]
The incidence of HCC is relatively lower in the Western Hemisphere than in Eastern Asia. However, despite the statistics being low, the diagnosis of HCC has increased since the 1980s and it is continuing to increase, making it one of the rising causes of death due to cancer. The common risk factor for HCC is hepatitis C, along with other health issues.[87][88]
Research
Preclinical
Mipsagargin (G-202), has orphan drug designation as a treatment during chemotherapy for HCC.[89] It is a thapsigargin-based prodrug with cytotoxic activity used to reduce blood flow to the tumor during treatment. Results from Phase 2 trial recommended G-202 as a first-in-class PSMA-targeted prodrug and that it move to clinical trials.[90]
Current research includes the search for the genes that are disregulated in HCC, antiheparanase antibodies,[91] protein markers,[92] non-coding RNAs[93] (such as TUC338)[94] and other predictive biomarkers.[95][96] As similar research is yielding results in various other malignant diseases, it is hoped that identifying the aberrant genes and the resultant proteins could lead to the identification of pharmacological interventions for HCC.[97]
The development of three-dimensional culture methods provides a new approach for preclinical studies of cancer therapy using patient-derived organoids. These miniaturized organoid 'avatars' of a patient's tumor recapitulate several features of the original tumor, rendering them an attractive model for drug-sensitivity testing and precision medicine for HCC and other types of primary liver cancer.[98]
Furthermore, HCC occurs in patients with liver disease. A biomarker named six-miRNA signature allows effective treatment of patients with HCC and is able to predict its recurrence in the liver.[99]
Clinical
JX-594, an oncolytic virus, has orphan drug designation for this condition and is undergoing clinical trials.[100] Hepcortespenlisimut-L (Hepko-V5), an oral cancer vaccine, also has US FDA orphan drug designation for HCC.[101] Immunitor Inc. completed a Phase II trial, published in 2017.[102] A randomized trial of people with advanced HCC showed no benefit for the combination of everolimus and pasireotide.[103]
See also
References
- ^ أ ب Shetty, Shrimati; Sharma, Nitika; Ghosh, Kanjaksha (2016-03-01). "Epidemiology of hepatocellular carcinoma (HCC) in hemophilia". Critical Reviews in Oncology/Hematology (in الإنجليزية). 99: 129–133. doi:10.1016/j.critrevonc.2015.12.009. ISSN 1040-8428. PMID 26754251.
- ^ Forner A, Llovet JM, Bruix J (2012). "Hepatocellular carcinoma". The Lancet. 379 (9822): 1245–1255. doi:10.1016/S0140-6736(11)61347-0. PMID 22353262. S2CID 24927898.
- ^ "Global Cancer Observatory". gco.iarc.fr. Retrieved 2021-06-24.
- ^ أ ب Kumar V, Fausto N, Abbas A, eds. (2015). Robbins & Cotran Pathologic Basis of Disease (9th ed.). Saunders. pp. 870–873. ISBN 978-1455726134.
- ^ أ ب "Liver cancer overview". Mayo Clinic.
- ^ أ ب Heidelbaugh, Joel J.; Bruderly, Michael (2006-09-01). "Cirrhosis and chronic liver failure: part I. Diagnosis and evaluation". American Family Physician. 74 (5): 756–762. ISSN 0002-838X. PMID 16970019.
- ^ Alter MJ (2007). "Epidemiology of hepatitis C virus infection". World Journal of Gastroenterology. 13 (17): 2436–41. doi:10.3748/wjg.v13.i17.2436. PMC 4146761. PMID 17552026.
{{cite journal}}: CS1 maint: unflagged free DOI (link) - ^ White DL, Kanwal F, El-Serag HB (2012). "Association between nonalcoholic fatty liver disease and risk for hepatocellular cancer, based on systematic review". Clinical Gastroenterology and Hepatology. 10 (12): 1342–59. doi:10.1016/j.cgh.2012.10.001. PMC 3501546. PMID 23041539.
- ^ "NAFLD vs. NASH". Medicine Specifics (in الإنجليزية الأمريكية). 2019-11-11. Retrieved 2021-06-22.
- ^ أ ب ت El–Serag HB; Hampel H; Javadi F (2006). "the association between diabetes and hepatocellular carcinoma: a systematic review of epidemiological evidence". Clinical Gastroenterology and Hepatology. 4 (3): 369–380. doi:10.1016/j.cgh.2005.12.007. PMID 16527702.
Diabetes is associated with an increased risk for HCC. However, more research is required to examine issues related to the duration and treatment of diabetes, and confounding by diet and obesity
- ^ Wang XW, Hussain SP, Huo TI, Wu CG, Forgues M, Hofseth LJ, Brechot C, Harris CC (2002). "Molecular pathogenesis of human hepatocellular carcinoma". Toxicology. 181–182: 43–47. doi:10.1016/S0300-483X(02)00253-6. PMID 12505283.
Recent studies in our laboratory have identified several potential factors that may contribute to the pathogenesis of HCC...For example, oxyradical overload diseases such as Wilson disease and hemochromatosis result in the generation of oxygen/nitrogen species that can cause mutations in the p53 tumour suppressor gene
- ^ Cheng W, Govindarajan S, Redeker A (1992). "Hepatocellular carcinoma in a case of Wilson's disease". Liver International. 12 (1): 42–45. doi:10.1111/j.1600-0676.1992.tb00553.x. PMID 1314321.
The patient described here was the oldest and only the third female patient with hepatocellular carcinoma complicating Wilson's disease to be reported in the literature
- ^ Wilkinson ML, Portmann B, Williams R (1983). "Wilson's disease and hepatocellular carcinoma: possible protective role of copper". Gut. 24 (8): 767–771. doi:10.1136/gut.24.8.767. PMC 1420230. PMID 6307837.
As copper has been shown to protect against chemically induced hepatocellular carcinoma in rats, this may be the reason for the extreme rarity of hepatocellular carcinoma in patients with Wilson's disease and possibly in other liver diseases with hepatic copper overload
- ^ Huang YC, Tsan YT, Chan WC, Wang JD, Chu WM, Fu YC, Tong KM, Lin CH, Chang ST, Hwang WL (2015). "Incidence and survival of cancers among 1,054 hemophilia patients: A nationwide and 14-year cohort study". American Journal of Hematology. 90 (4): E55–E59. doi:10.1002/ajh.23947. PMID 25639564.
- ^ Tanaka M, Katayama F, Kato H, Tanaka H, Wang J, Qiao YL, Inoue M (2011). "Hepatitis B and C virus infection and hepatocellular carcinoma in China: A review of epidemiology and control measures". Journal of Epidemiology. 21 (6): 401–416. doi:10.2188/jea.JE20100190. PMC 3899457. PMID 22041528.
- ^ أ ب ت ث ج ح خ د ذ ر Balogh J, Victor D, Asham E, Burroughs S, Boktour M, Saharia A, Li X, Ghobrial M, Monsour H (2016). "Hepatocellular carcinoma: a review". Journal of Hepatocellular Carcinoma. 3: 41–53. doi:10.2147/JHC.S61146. PMC 5063561. PMID 27785449.
{{cite journal}}: CS1 maint: unflagged free DOI (link) - ^ "Pathophysiology". 2019-11-10. Retrieved May 12, 2010.
{{cite journal}}: Cite journal requires|journal=(help) - ^ أ ب ت Hassan MM, Curley SA, Li D, Kaseb A, Davila M, Abdalla EK, Javle M, Moghazy DM, Lozano RD, Abbruzzese JL, Vauthey JN (2010). "Association of diabetes duration and diabetes treatment with the risk of hepatocellular carcinoma". Cancer. 116 (8): 1938–1946. doi:10.1002/cncr.24982. PMC 4123320. PMID 20166205.
Diabetes appears to increase the risk of HCC, and such risk is correlated with a long duration of diabetes. Relying on dietary control and treatment with sulfonylureas or insulin were found to confer the highest magnitude of HCC risk, whereas treatment with biguanides or thiazolidinediones was associated with a 70% HCC risk reduction among diabetics.
- ^ أ ب Donadon, Valter (2009). "Antidiabetic therapy and increased risk of hepatocellular carcinoma in chronic liver disease". World Journal of Gastroenterology. 15 (20): 2506–11. doi:10.3748/wjg.15.2506. PMC 2686909. PMID 19469001.
Our study confirms that type 2 diabetes mellitus is an independent risk factor for HCC and pre-exists in the majority of HCC patients. Moreover, in male patients with type 2 diabetes mellitus, our data shows a direct association of HCC with insulin and sulphanylureas treatment and an inverse relationship with metformin therapy.
{{cite journal}}: CS1 maint: unflagged free DOI (link) - ^ Donadon V, Balbi M, Ghersetti M, et al. (2009). "Antidiabetic therapy and increased risk of hepatocellular carcinoma in chronic liver disease". World Journal of Gastroenterology. 15 (20): 2506–11. doi:10.3748/wjg.15.2506. PMC 2686909. PMID 19469001.
{{cite journal}}: CS1 maint: unflagged free DOI (link) - ^ Siegel A, Zhu AX (2009). "Metabolic Syndrome and hepatocellular carcinoma". Cancer. 115 (24): 5651–5661. doi:10.1002/cncr.24687. PMC 3397779. PMID 19834957.
The majority of 'cryptogenic' HCC in the United States is attributed to nonalcoholic fatty liver disease (NAFLD), a hepatic manifestation of the metabolic syndrome... It is predicted that metabolic syndrome will lead to large increases in the incidence of HCC over the next decades. A better understanding of the relation between these two diseases ultimately should lead to improved screening and treatment options for patients with HCC.
- ^ Stickely F, Hellerbrand C (2010). "Non-alcoholic fatty liver disease as a risk factor for hepatocellular carcinoma: mechanisms and implications". Gut. 59 (10): 1303–1307. doi:10.1136/gut.2009.199661. PMID 20650925. S2CID 31016985.
Based on the known association of NAFLD with IR and MS, approximately two-thirds of the patients were obese and/or diabetic, 4 and a remarkable 25% of these patients had no cirrhosis... Therefore, it is particularly worrying that the most persuasive evidence for an association between NAFLD and HCC derives from studies on the risk of HCC in patients with metabolic syndrome
- ^ "Hepatocellular Carcinoma and Diseases". Retrieved May 12, 2010.
- ^ Höpfner M, Huether A, Sutter AP, Baradari V, Schuppan D, Scherübl H (2006). "Blockade of IGF-1 receptor tyrosine kinase has antineoplastic effects in hepatocellular carcinoma cells". Biochemical Pharmacology. 71 (10): 1435–1448. doi:10.1016/j.bcp.2006.02.006. PMID 16530734.
Inhibition of IGF-1R tyrosine kinase (IGF-1R-TK) by NVP-AEW541 induces growth inhibition, apoptosis and cell cycle arrest in human HCC cell lines without accompanying cytotoxicity. Thus, IGF-1R-TK inhibition may be a promising novel treatment approach in HCC.
- ^ Huynh H, Chow PK, Ooi LL, Soo KC (2002). "A possible role for insulin-like growth factor-binding protein-3 autocrine/paracrine loops in controlling hepatocellular carcinoma cell proliferation". Cell Growth & Differentiation. 13 (3): 115–122. PMID 11959812.
Our data indicate that loss of autocrine/paracrine IGFBP-3 loops may lead to HCC tumor growth and suggest that modulating production of the IGFs, IGFBP-3, and IGF-IR may represent a novel approach in the treatment of HCC.
- ^ Martin NM, Abu Dayyeh BK, Chung RT (2008). "Anabolic steroid abuse causing recurrent hepatic adenomas and hemorrhage". World Journal of Gastroenterology. 14 (28): 4573–4575. doi:10.3748/wjg.14.4573. PMC 2731289. PMID 18680242.
This is the first reported case of hepatic adenoma re-growth with recidivistic steroid abuse, complicated by life-threatening hemorrhage.
{{cite journal}}: CS1 maint: unflagged free DOI (link) - ^ Gorayski P, Thompson CH, Subhash HS, Thomas AC (2007). "Hepatocellular carcinoma associated with recreational anabolic steroid use". British Journal of Sports Medicine. 42 (1): 74–75. doi:10.1136/bjsm.2007.03932. PMID 18178686. S2CID 21900098.
Malignant transformation to HCC from a pre-existing hepatic adenoma confirmed by immunohistochemical study has previously not been reported in athletes taking anabolic steroids. Further studies using screening programmes to identify high-risk individuals are recommended.
- ^ Shibata T, Aburatani H (2014). "Exploration of liver cancer genomes". Nat Rev Gastroenterol Hepatol. 11 (6): 340–9. doi:10.1038/nrgastro.2014.6. PMID 24473361. S2CID 8611393.
- ^ Chien-Jen Chen; Hwai-I. Yang; Jun Su; Chin-Lan Jen; San-Lin You; Sheng-Nan Lu; Guan-Tarn Huang; Uchenna H. Iloeje (2006). "Risk of Hepatocellular Carcinoma Across a Biological Gradient of Serum Hepatitis B Virus DNA Level". JAMA. 295 (1): 65–73. doi:10.1001/jama.295.1.65. PMID 16391218.
- ^ Yang SF, Chang CW, Wei RJ, Shiue YL, Wang SN, Yeh YT (2014). "Involvement of DNA damage response pathways in hepatocellular carcinoma". Biomed Res Int. 2014: 1–18. doi:10.1155/2014/153867. PMC 4022277. PMID 24877058.
- ^ Nishida N, Kudo M (2013). "Oxidative stress and epigenetic instability in human hepatocarcinogenesis". Dig Dis. 31 (5–6): 447–53. doi:10.1159/000355243. PMID 24281019.
- ^ أ ب Heimbach, Julie K.; Kulik, Laura M.; Finn, Richard; Sirlin, Claude B.; Abecassis, Michael; Roberts, Lewis R.; Zhu, Andrew; Murad, M. Hassan; Marrero, Jorge (2017-01-01). "Aasld guidelines for the treatment of hepatocellular carcinoma". Hepatology (in الإنجليزية). 67 (1): 358–380. doi:10.1002/hep.29086. ISSN 1527-3350. PMID 28130846.
- ^ "Clinical features and diagnosis of primary hepatocellular carcinoma". UptoDate. Retrieved 4 February 2014.
- ^ أ ب ت Colli, A; Fraquelli, M; Casazza, G; Massironi, S; Colucci, A; Conte, D; Duca, P (March 2006). "Accuracy of ultrasonography, spiral CT, magnetic resonance, and alpha-fetoprotein in diagnosing hepatocellular carcinoma: a systematic review". The American Journal of Gastroenterology. 101 (3): 513–23. doi:10.1111/j.1572-0241.2006.00467.x. PMID 16542288. S2CID 9563077.
{{cite journal}}: CS1 maint: multiple names: authors list (link) - ^ Ertle, JM; Heider, D; Wichert, M; Keller, B; Kueper, R; Hilgard, P; Gerken, G; Schlaak, JF (2013). "A combination of α-fetoprotein and des-γ-carboxy prothrombin is superior in detection of hepatocellular carcinoma". Digestion. 87 (2): 121–31. doi:10.1159/000346080. PMID 23406785. S2CID 25266129.
- ^ "Benign Liver Tumors". The Lecturio Medical Concept Library. Retrieved 4 July 2021.
- ^ El-Serag HB, Marrero JA, Rudolph L, Reddy KR (May 2008). "Diagnosis and treatment of hepatocellular carcinoma". Gastroenterology. 134 (6): 1752–63. doi:10.1053/j.gastro.2008.02.090. PMID 18471552. S2CID 10418520.
- ^ "Li-Rads". Archived from the original on 2017-07-11. Retrieved 2014-02-04.
- ^ Hepatocellular carcinoma (Photo) Archived 2021-11-01 at the Wayback Machine ATLAS OF PATHOLOGY
- ^ Chan AW, Zhang Z, Chong CC, Tin EK, Chow C, Wong N (2019). "Genomic landscape of lymphoepithelioma-like hepatocellular carcinoma". J Pathol. 249 (2): 166–172. doi:10.1002/path.5313. PMID 31168847. S2CID 174815950.
{{cite journal}}: CS1 maint: multiple names: authors list (link) - ^ Chan AW, Tong JH, Pan Y, Chan SL, Wong GL, Wong VW, Lai PB, To KF (2015). "Lymphoepithelioma-like hepatocellular carcinoma: an uncommon variant of hepatocellular carcinoma with favorable outcome". Am J Surg Pathol. 39 (3): 304–312. doi:10.1097/pas.0000000000000376. PMID 25675010. S2CID 40384842.
{{cite journal}}: CS1 maint: multiple names: authors list (link) - ^ أ ب Duseja, Ajay (2014-08-01). "Staging of Hepatocellular Carcinoma". Journal of Clinical and Experimental Hepatology. 4 (Suppl 3): S74–S79. doi:10.1016/j.jceh.2014.03.045. PMC 4284240. PMID 25755615.
- ^ Llovet JM, Brú C, Bruix J (1999). "Prognosis of hepatocellular carcinoma: the BCLC staging classification". Seminars in Liver Disease. 19 (3): 329–38. doi:10.1055/s-2007-1007122. PMID 10518312.
- ^ "BCLC staging system and the Child-Pugh system ;Liver cancer ; Cancer Research UK". www.cancerresearchuk.org.
- ^ "What is the Barcelona Clinic Liver Cancer (BCLC) system for hepatocellular carcinoma (HCC) staging?". www.medscape.com.
- ^ Kinoshita, A; Onoda, H; Fushiya, N; Koike, K; Nishino, H; Tajiri, H (27 March 2015). "Staging systems for hepatocellular carcinoma: Current status and future perspectives". World Journal of Hepatology. 7 (3): 406–24. doi:10.4254/wjh.v7.i3.406. PMC 4381166. PMID 25848467.
{{cite journal}}: CS1 maint: unflagged free DOI (link) - ^ Katyal, Sanjeev; Oliver, James H.; Peterson, Mark S.; Ferris, James V.; Carr, Brian S.; Baron, Richard L. (2000). "Extrahepatic Metastases of Hepatocellular Carcinoma". Radiology. 216 (3): 698–703. doi:10.1148/radiology.216.3.r00se24698. PMID 10966697.
- ^ "Hepatitis B: Prevention and treatment". Archived from the original on 24 July 2013. Retrieved 28 August 2013. "WHO aims at controlling HBV worldwide to decrease the incidence of HBV-related chronic liver disease, cirrhosis, and hepatocellular carcinoma. by integrating HB vaccination into routine infant (and possibly adolescent) immunization programs."
- ^ "Prevention". Retrieved May 12, 2010.
- ^ Kansagara, Devan; Papak, Joel; Pasha, Amirala S.; O'Neil, Maya; Freeman, Michele; Relevo, Rose; Quiñones, Ana; Motu'apuaka, Makalapua; et al. (17 June 2014). "Screening for Hepatocellular Carcinoma in Chronic Liver Disease". Annals of Internal Medicine. 161 (4): 261–9. doi:10.7326/M14-0558. PMID 24934699.
- ^ أ ب Pompili, Maurizio (2013). "Bridging and downstaging treatments for hepatocellular carcinoma in patients on the waiting list for liver transplantation". World Journal of Gastroenterology. 19 (43): 7515–30. doi:10.3748/wjg.v19.i43.7515. PMC 3837250. PMID 24282343.
{{cite journal}}: CS1 maint: unflagged free DOI (link) - ^ Gbolahan, Olumide B.; Schacht, Michael A.; Beckley, Eric W.; LaRoche, Thomas P.; O'Neil, Bert H.; Pyko, Maximilian (April 2017). "Locoregional and systemic therapy for hepatocellular carcinoma". Journal of Gastrointestinal Oncology. 8 (2): 215–228. doi:10.21037/jgo.2017.03.13. ISSN 2078-6891. PMC 5401862. PMID 28480062.
{{cite journal}}: CS1 maint: unflagged free DOI (link) - ^ Marrero, JA; Kulik, LM; Sirlin, CB; Zhu, AX; Finn, RS; Abecassis, MM; Roberts, LR; Heimbach, JK (August 2018). "Diagnosis, Staging, and Management of Hepatocellular Carcinoma: 2018 Practice Guidance by the American Association for the Study of Liver Diseases" (PDF). Hepatology. 68 (2): 723–750. doi:10.1002/hep.29913. PMID 29624699. S2CID 4666537.
- ^ Ma, Ka Wing; Cheung, Tan To (December 2016). "Surgical resection of localized hepatocellular carcinoma: patient selection and special consideration". Journal of Hepatocellular Carcinoma. 4: 1–9. doi:10.2147/JHC.S96085. PMC 5207474. PMID 28097107.
{{cite journal}}: CS1 maint: unflagged free DOI (link) - ^ Ang, Soo Fan; Ng, Elizabeth Shu-Hui; Li, Huihua; Ong, Yu-Han; Choo, Su Pin; Ngeow, Joanne; Toh, Han Chong; Lim, Kiat Hon; Yap, Hao Yun; Tan, Chee Kiat; Ooi, London Lucien Peng Jin; Chung, Alexander Yaw Fui; Chow, Pierce Kah Hoe; Foo, Kian Fong; Tan, Min-Han; Cheow, Peng Chung (2015). "The Singapore Liver Cancer Recurrence (SLICER) Score for Relapse Prediction in Patients with Surgically Resected Hepatocellular Carcinoma". PLOS ONE. 10 (4): e0118658. Bibcode:2015PLoSO..1018658A. doi:10.1371/journal.pone.0118658. PMC 4382157. PMID 25830231.
- ^ Fan, Jia; Yang, Guang-Shun; Fu, Zhi-Ren; Peng, Zhi-Hai; Xia, Qiang; Peng, Chen-Hong; Qian, Jian-Ming; Zhou, Jian; Xu, Yang; et al. (2009). "Liver transplantation outcomes in 1,078 hepatocellular carcinoma patients: a multi-center experience in Shanghai, China". Journal of Cancer Research and Clinical Oncology. 135 (10): 1403–1412. doi:10.1007/s00432-009-0584-6. PMID 19381688. S2CID 1216580.
- ^ Vitale, Alessandro; Gringeri, Enrico; Valmasoni, Michele; D'Amico, Francesco; Carraro, Amedeo; Pauletto, Alberto; D'Amico, Francesco Jr.; Polacco, Marina; D'Amico, Davide Francesco; Cillo, Umberto (2007). "Longterm results of liver transplantation for hepatocellular carcinoma: an update of the University of Padova experience". Transplantation Proceedings. 39 (6): 1892–1894. doi:10.1016/j.transproceed.2007.05.031. PMID 17692645.
{{cite journal}}: CS1 maint: multiple names: authors list (link) - ^ Obed, Aiman; Tsui, Tung-Yu; Schnitzbauer, Andreas A.; Obed, Manal; Schlitt, Hans J.; Becker, Heinz; Lorf, Thomas (2009). "Liver Transplantation for Hepatocellular Carcinoma: Need for a New Patient Selection Strategy: Reply". Langenbeck's Archives of Surgery. 393 (2): 141–147. doi:10.1007/s00423-007-0250-x. PMC 1356504. PMID 18043937.
- ^ Michelakos, T; Xourafas, D; Qadan, M; Pieretti-Vanmarcke, R; Cai, L; Patel, MS; Adler, JT; Fontan, F; Basit, U; Vagefi, PA; Elias, N; Tanabe, KK; Berger, D; Yeh, H; Markmann, JF; Chang, DC; Ferrone, CR (June 2019). "Hepatocellular Carcinoma in Transplantable Child-Pugh A Cirrhotics: Should Cost Affect Resection vs Transplantation?". Journal of Gastrointestinal Surgery. 23 (6): 1135–1142. doi:10.1007/s11605-018-3946-z. PMID 30218342. S2CID 52275656.
- ^ Cillo, Umberto; Vitale, Alessandro; Bassanello, Marco; Boccagni, Patrizia; Brolese, Alberto; Zanus, Giacomo; Burra, Patrizia; Fagiuoli, Stefano; Farinati, Fabio; Rugge, Massimo; d'Amico, Davide Francesco (February 2004). "Liver transplantation for the treatment of moderately or well-differentiated hepatocellular carcinoma". Annals of Surgery. 239 (2): 150–9. doi:10.1097/01.sla.0000109146.72827.76. PMC 1356206. PMID 14745321.
- ^ Tanabe, KK; Curley, SA; Dodd, GD; Siperstein, AE; Goldberg, SN (February 1, 2004). "Radiofrequency ablation: the experts weigh in". Cancer. 100 (3): 641–50. doi:10.1002/cncr.11919. PMID 14745883.
{{cite journal}}: CS1 maint: multiple names: authors list (link) - ^ Tateishi, R; Shiina, S; Teratani, T; Obi, S; Sato, S; Koike, Y; Fujishima, T; Yoshida, H; Kawabe, T; Omata, M (15 March 2005). "Percutaneous radiofrequency ablation for hepatocellular carcinoma. An analysis of 1000 cases". Cancer. 103 (6): 1201–9. doi:10.1002/cncr.20892. PMID 15690326. S2CID 37178385.
{{cite journal}}: CS1 maint: multiple names: authors list (link) - ^ Chen, Min-Shan; Li, Jin-Qing; Zheng, Yun; Guo, Rong-Ping; Liang, Hui-Hong; Zhang, Ya-Qi; Lin, Xiao-Jun; Lau, Wan Y (2006). "A Prospective Randomized Trial Comparing Percutaneous Local Ablative Therapy and Partial Hepatectomy for Small Hepatocellular Carcinoma". Annals of Surgery. 243 (3): 321–8. doi:10.1097/01.sla.0000201480.65519.b8. PMC 1448947. PMID 16495695.
- ^ Yamamoto, Junji; Okada, Shuichi; Shimada, Kazuaki; Okusaka, Takushi; Yamasaki, Susumu; Ueno, Hideki; Kosuge, Tomoo (2001). "Treatment strategy for small hepatocellular carcinoma: Comparison of long-term results after percutaneous ethanol injection therapy and surgical resection". Hepatology. 34 (4): 707–713. doi:10.1053/jhep.2001.27950. PMID 11584366.
- ^ "Interventional Radiology Treatments for Liver Cancer". Society of Interventional Radiology. Archived from the original on 8 February 2014. Retrieved 4 February 2014.
- ^ Kooby, DA; Egnatashvili, V; Srinivasan, S; Chamsuddin, A; Delman, KA; Kauh, J; Staley CA, 3rd; Kim, HS (February 2010). "Comparison of yttrium-90 radioembolization and transcatheter arterial chemoembolization for the treatment of unresectable hepatocellular carcinoma". Journal of Vascular and Interventional Radiology. 21 (2): 224–30. doi:10.1016/j.jvir.2009.10.013. PMID 20022765.
{{cite journal}}: CS1 maint: multiple names: authors list (link) CS1 maint: numeric names: authors list (link) - ^ "Hepatocellular Carcinoma (HCC) and Liver Metastases". The Lecturio Medical Concept Library. Retrieved 4 July 2021.
- ^ Jonathan Klein (2012). "Hepatocellular Carcinoma Radiation Therapy: Review of Evidence and Future Opportunities". Nt J Radiation Oncol Biol Phys. 87 (1): 22–32. doi:10.1016/j.ijrobp.2012.08.043. PMID 23219567.
- ^ Mutlay Sayan (2019). "Rethinking the Role of Radiation Therapy in the Treatment of Unresectable Hepatocellular Carcinoma: A Data Driven Treatment Algorithm for Optimizing Outcomes". Front. Oncol. 9: 345. doi:10.3389/fonc.2019.00345. PMC 6591511. PMID 31275846.
- ^ Nina N Sanford (2018). "Protons versus Photons for Unresectable Hepatocellular Carcinoma: Liver Decompensation and Overall Survival". Int J Radiation Oncol Biol Phys. 105 (1): 64–72. doi:10.1016/j.ijrobp.2019.01.076. PMID 30684667.
- ^ "Radiation Therapy With Protons or Photons in Treating Patients With Liver Cancer". ClinicalTrials.gov. 21 Aug 2020.
- ^ Lin, Shi-Ming (21 Aug 2020). "Proton Radiotherapy Versus Radiofrequency Ablation for Patients With Medium or Large Hepatocellular Carcinoma". ClinicalTrials.gov.
- ^ Md, Michael Devera (21 Aug 2020). "Transarterial Chemoembolization Versus Proton Beam Radiotherapy for the Treatment of Hepatocellular Carcinoma". ClinicalTrials.gov.
- ^ أ ب Llovet, Josep M.; Ricci, Sergio; Mazzaferro, Vincenzo; Hilgard, Philip; Gane, Edward; Blanc, Jean-Frédéric; de Oliveira, Andre Cosme; Santoro, Armando; Raoul, Jean-Luc (2008-07-24). "Sorafenib in Advanced Hepatocellular Carcinoma". New England Journal of Medicine. 359 (4): 378–390. CiteSeerX 10.1.1.531.1130. doi:10.1056/nejmoa0708857. ISSN 0028-4793. PMID 18650514.
- ^ أ ب Cheng, Ann-Lii; Kang, Yoon-Koo; Chen, Zhendong; Tsao, Chao-Jung; Qin, Shukui; Kim, Jun Suk; Luo, Rongcheng; Feng, Jifeng; Ye, Shenglong (January 2009). "Efficacy and safety of sorafenib in patients in the Asia-Pacific region with advanced hepatocellular carcinoma: a phase III randomised, double-blind, placebo-controlled trial". The Lancet. Oncology. 10 (1): 25–34. doi:10.1016/S1470-2045(08)70285-7. ISSN 1474-5488. PMID 19095497.
- ^ Kudo, Masatoshi (2017). "Systemic Therapy for Hepatocellular Carcinoma: 2017 Update". Oncology (in الإنجليزية). 93 (1): 135–146. doi:10.1159/000481244. ISSN 0030-2414. PMID 29258077.
- ^ Finn, Richard S.; Qin, Shukui; Ikeda, Masafumi; Galle, Peter R.; Ducreux, Michel; Kim, Tae-You; Kudo, Masatoshi; Breder, Valeriy; Merle, Philippe; Kaseb, Ahmed O.; Li, Daneng; Verret, Wendy; Xu, Derek-Zhen; Hernandez, Sairy; Liu, Juan; Huang, Chen; Mulla, Sohail; Wang, Yulei; Lim, Ho Yeong; Zhu, Andrew X.; Cheng, Ann-Lii (2020). "Atezolizumab plus Bevacizumab in Unresectable Hepatocellular Carcinoma". New England Journal of Medicine. 382 (20): 1894–1905. doi:10.1056/nejmoa1915745. PMID 32402160. S2CID 218633632.
- ^ أ ب "Imjudo (tremelimumab) in combination with Imfinzi approved in the US for patients with unresectable liver cancer". AstraZeneca (Press release). 26 October 2022. Retrieved 26 October 2022.
- ^ Madoff, DC; Hicks, ME; Vauthey, JN; Charnsangavej, C; Morello FA, Jr; Ahrar, K; Wallace, MJ; Gupta, S (September–October 2002). "Transhepatic portal vein embolization: anatomy, indications, and technical considerations". Radiographics. 22 (5): 1063–76. doi:10.1148/radiographics.22.5.g02se161063. PMID 12235336.
{{cite journal}}: CS1 maint: multiple names: authors list (link) - ^ Vente MA, Wondergem M, van der Tweel I, et al. (April 2009). "Yttrium-90 microsphere radioembolization for the treatment of liver malignancies: a structured meta-analysis". European Radiology. 19 (4): 951–9. doi:10.1007/s00330-008-1211-7. PMID 18989675.
- ^ Hepatocellular carcinoma Archived 2016-07-05 at the Wayback Machine MedlinePlus, Medical Encyclopedia
- ^ "WHO Disease and injury country estimates". World Health Organization. 2009. Retrieved November 11, 2009.
- ^ Table 37.2 Archived 2020-02-24 at the Wayback Machine in: Sternberg, Stephen (2012). Sternberg's diagnostic surgical pathology. Place of publication not identified: LWW. ISBN 978-1-4511-5289-0. OCLC 953861627.
- ^ أ ب Kumar V, Fausto N, Abbas A (editors) (2015). Robbins & Cotran Pathologic Basis of Disease (9th ed.). Elsevier/Saunders. pp. 821–881. ISBN 9780323266161.
{{cite book}}:|author=has generic name (help)CS1 maint: multiple names: authors list (link) - ^ "Cancer". World Health Organization. February 2006. Retrieved 2007-05-24.
- ^ Rowe, JulieH; Ghouri, YezazAhmed; Mian, Idrees (2017-01-01). "Review of hepatocellular carcinoma: Epidemiology, etiology, and carcinogenesis". Journal of Carcinogenesis (in الإنجليزية). 16 (1): 1. doi:10.4103/jcar.jcar_9_16. PMC 5490340. PMID 28694740.
{{cite journal}}: CS1 maint: unflagged free DOI (link) - ^ Choo, Su Pin; Tan, Wan Ling; Goh, Brian K. P.; Tai, Wai Meng; Zhu, Andrew X. (15 November 2016). "Comparison of hepatocellular carcinoma in Eastern versus Western populations". Cancer. 122 (22): 3430–3446. doi:10.1002/cncr.30237. PMID 27622302. S2CID 42804844.
- ^ Goh, George Boon-Bee; Chang, Pik-Eu; Tan, Chee-Kiat (December 2015). "Changing epidemiology of hepatocellular carcinoma in Asia". Best Practice & Research Clinical Gastroenterology. 29 (6): 919–928. doi:10.1016/j.bpg.2015.09.007. PMID 26651253.
- ^ phyton (2016-08-22). "Phyton Biotech Achieves Manufacturing Milestone with Thapsigargin, the Active Agent in Mipsagargin". Phyton Biotech (in الإنجليزية الأمريكية). Retrieved 2020-04-10.
- ^ Mahalingam, Devalingam; Peguero, Julio; Cen, Putao; Arora, Sukeshi P.; Sarantopoulos, John; Rowe, Julie; Allgood, Victoria; Tubb, Benjamin; Campos, Luis (2019-06-17). "A Phase II, Multicenter, Single-Arm Study of Mipsagargin (G-202) as a Second-Line Therapy Following Sorafenib for Adult Patients with Progressive Advanced Hepatocellular Carcinoma". Cancers. 11 (6): 833. doi:10.3390/cancers11060833. ISSN 2072-6694. PMC 6627768. PMID 31212948.
- ^ Yang, Jian-min; Wang, Hui-ju; Du, Ling; Han, Xiao-mei; Ye, Zai-yuan; Fang, Yong; Tao, Hou-quan; Zhao, Zhong-sheng; Zhou, Yong-lie (2009-01-25). "Screening and identification of novel B cell epitopes in human heparanase and their anti-invasion property for hepatocellular carcinoma". Cancer Immunology, Immunotherapy. 58 (9): 1387–1396. doi:10.1007/s00262-008-0651-x. PMID 19169879. S2CID 19074169.
- ^ "Huntington Medical Research Institute News, May 2005" (PDF). Archived from the original (PDF) on December 10, 2005.
- ^ Klingenberg, Marcel; Matsuda, Akiko; Diederichs, Sven; Patel, Tushar (September 2017). "Non-coding RNA in hepatocellular carcinoma: Mechanisms, biomarkers and therapeutic targets". Journal of Hepatology. 67 (3): 603–618. doi:10.1016/j.jhep.2017.04.009. ISSN 1600-0641. PMID 28438689.
- ^ Braconi, C; Valeri, N, Kogure, T, Gasparini, P, Huang, N, Nuovo, GJ, Terracciano, L, Croce, CM, Patel, T (2011-01-11). "Expression and functional role of a transcribed noncoding RNA with an ultraconserved element in hepatocellular carcinoma". Proceedings of the National Academy of Sciences of the United States of America. 108 (2): 786–91. Bibcode:2011PNAS..108..786B. doi:10.1073/pnas.1011098108. PMC 3021052. PMID 21187392.
{{cite journal}}: CS1 maint: multiple names: authors list (link) - ^ "Journal of Clinical Oncology, Special Issue on Molecular Oncology: Receptor-Based Therapy, April 2005". Archived from the original on 2005-11-30. Retrieved 2005-08-31.
- ^ Lau W, Leung T, Ho S, Chan M, Machin D, Lau J, Chan A, Yeo W, Mok T, Yu S, Leung N, Johnson P (1999). "Adjuvant intra-arterial iodine-131-labelled lipiodol for resectable hepatocellular carcinoma: a prospective randomised trial". The Lancet. 353 (9155): 797–801. doi:10.1016/S0140-6736(98)06475-7. PMID 10459961. S2CID 54270315.
- ^ Thomas M, Zhu A (2005). "Hepatocellular carcinoma: the need for progress". Journal of Clinical Oncology. 23 (13): 2892–9. doi:10.1200/JCO.2005.03.196. PMID 15860847. Archived from the original on 2005-11-05. Retrieved 2005-08-29.
- ^ Broutier L, Mastrogiovanni G, Verstegen MM, Francies HE, Gavarró LM, Bradshaw CR, Allen GE, Arnes-Benito R, Sidorova O, Gaspersz MP, Georgakopoulos N, Koo BK, Dietmann S, Davies SE, Praseedom RK, Lieshout R, IJzermans JNM, Wigmore SJ, Saeb-Parsy K, Garnett MJ, van der Laan LJ, Huch M (2017). "Human primary liver cancer-derived organoid cultures for disease modeling and drug screening". Nat Med. 23 (12): 1424–1435. doi:10.1038/nm.4438. PMC 5722201. PMID 29131160.
{{cite journal}}: CS1 maint: multiple names: authors list (link) - ^ Fumao, B; Zhou, H; Ma, M; Guan, C; Lyu, J; Meng, QH (2 May 2018). "A novel RNA-sequencing-based miRNA signature predicts with recurrence and outcome of hepatocellular carcinoma". Molecular Oncology. 12 (7): 1125–1137. doi:10.1002/1878-0261.12315. PMC 6026871. PMID 29719937.
- ^ "ennerex Granted FDA Orphan Drug Designation for Pexa-Vec in Hepatocellular Carcinoma (HCC)". Archived from the original on March 25, 2014.
- ^ "Enforcement Reports". www.accessdata.fda.gov.
- ^ Tarakanovskaya, M. G; Chinburen, J; Batchuluun, P; Munkhzaya, C; Purevsuren, G; Dandii, D; Hulan, T; Oyungerel, D; Kutsyna, G. A; Reid, A. A; Borisova, V; Bain, A. I; Jirathitikal, V; Bourinbaiar, A. S (2017). "Open-label Phase II clinical trial in 75 patients with advanced hepatocellular carcinoma receiving daily dose of tableted liver cancer vaccine, hepcortespenlisimut-L". Journal of Hepatocellular Carcinoma. 4: 59–69. doi:10.2147/JHC.S122507. PMC 5396941. PMID 28443252.
{{cite journal}}: CS1 maint: unflagged free DOI (link) - ^ Sanoff, Hanna K.; Kim, Richard; Ivanova, Anastasia; Alistar, Angela; McRee, Autumn J.; O’Neil, Bert H. (2015). "Everolimus and pasireotide for advanced and metastatic hepatocellular carcinoma". Investigational New Drugs. 33 (2): 505–509. doi:10.1007/s10637-015-0209-7. PMC 4487887. PMID 25613083.
Further reading
- "Long-term results of liver transplantation for hepatocellular carcinoma: an update of the University of Padova experience". September 23, 2013. Retrieved 6 February 2014.
- Bruix, Jordi; Sherman, Morris; Practice Guidelines Committee (November 2005). "Management of hepatocellular carcinoma". Hepatology. 42 (5): 1208–1236. doi:10.1002/hep.20933. PMID 16250051. S2CID 5106445.
- Liu, Chi-leung, M.D., "Hepatic Resection for Hepatocellular Carcinoma", The Hong Kong Medical Diary, Vol.10 No.12, December 2005 Medical Bulletin
External links
- Blue Faery: The Adrienne Wilson Liver Cancer Association (hepatocellular carcinoma patient support site)
- NCI Liver Cancer Homepage
| Classification | |
|---|---|
| External resources |
- CS1 maint: unflagged free DOI
- CS1 الإنجليزية الأمريكية-language sources (en-us)
- CS1 maint: numeric names: authors list
- CS1 errors: generic name
- الصفحات بخصائص غير محلولة
- Short description is different from Wikidata
- Articles with unsourced statements from May 2021
- Articles with unsourced statements from March 2022
- Articles with unsourced statements from November 2022
- Articles with unsourced statements from August 2020
- مقالات ذات عبارات بحاجة لمصادر
- Articles with unsourced statements from November 2019
- صفحات بها وصلات إنترويكي
- Digestive system neoplasia
- Hepatology
- Infectious causes of cancer
- Hepatitis C virus-associated diseases